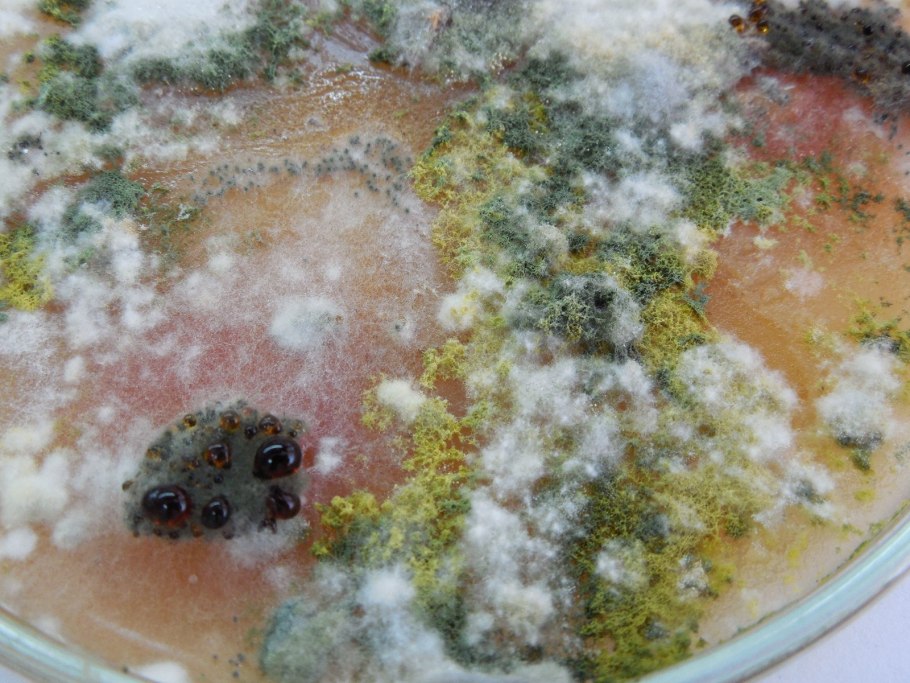
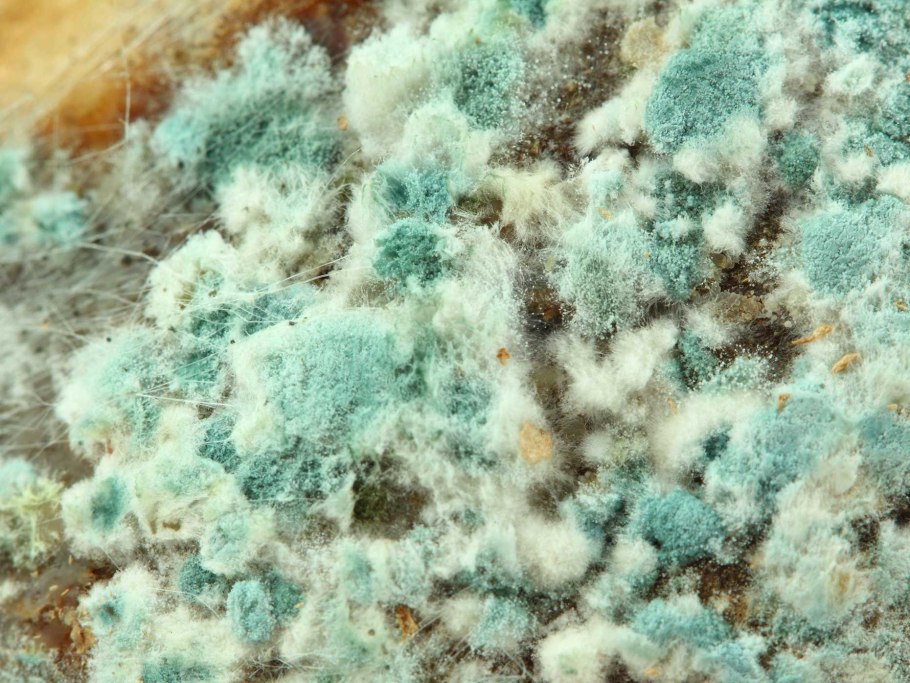
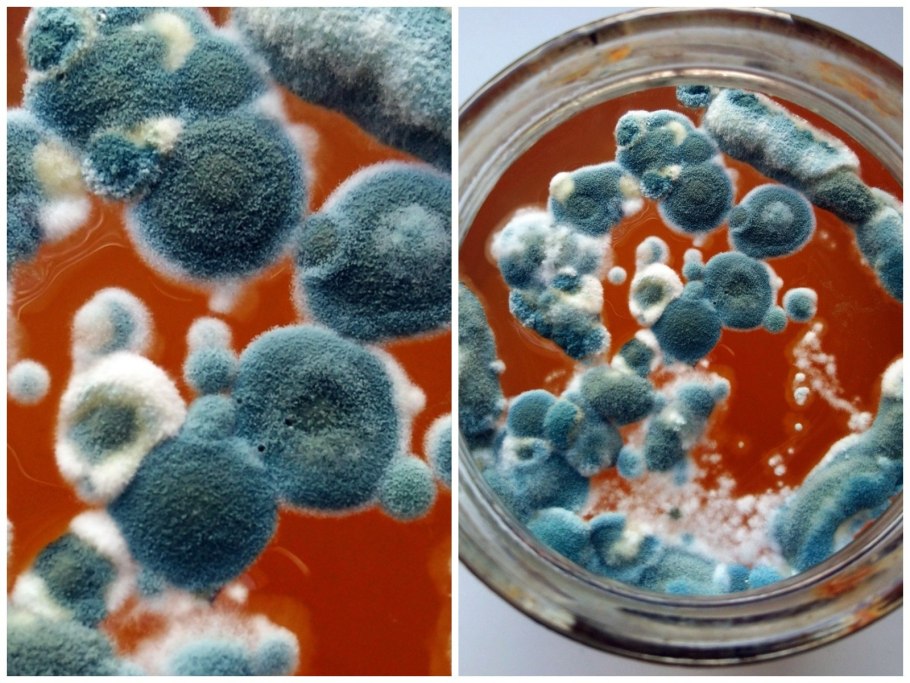
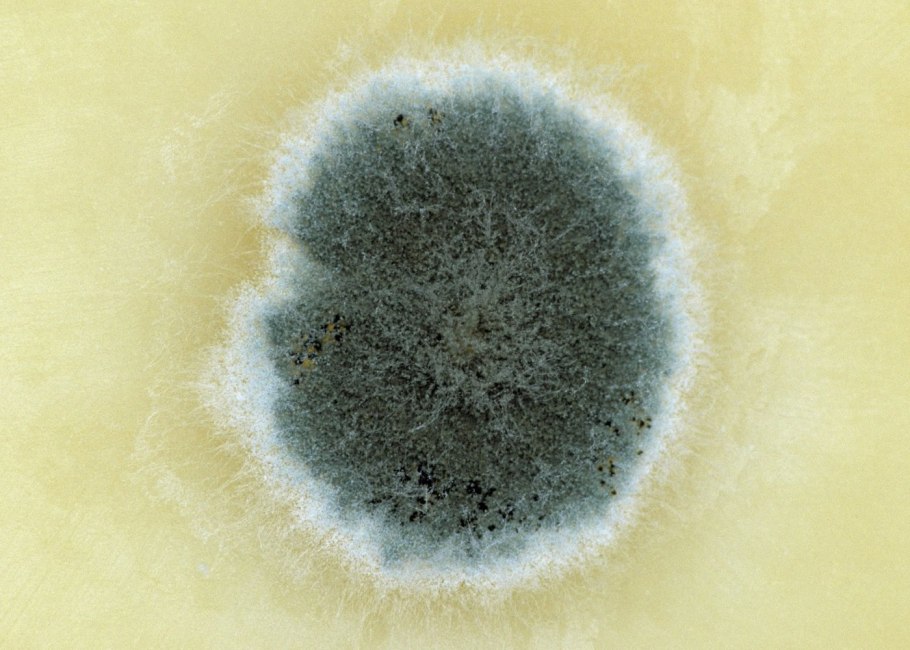
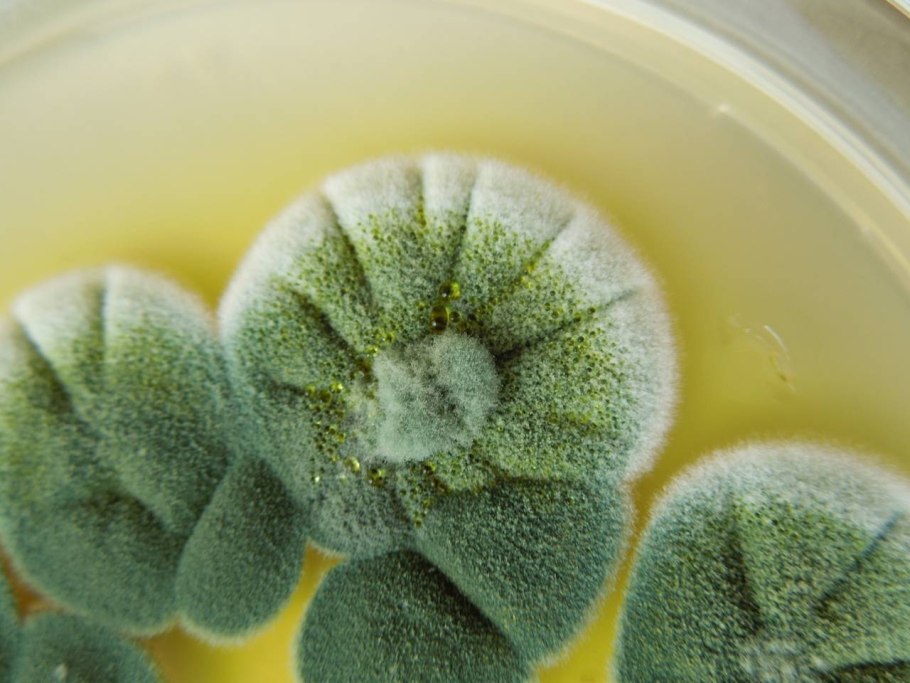

Валлемия плесень

Гриб пеницилл на хлебе

Плесени/плесневые грибы

Плесень гриб мукор
Триходерма Петри

Плесень на продуктах

Необычная плесень

Зеленая плесень пеницилл на хлебе

Зеленая плесень пеницилл на хлебе
Плесень bipolaris

Микоз черная плесень

Ulocladium плесень

Плесневелые грибы микробиология

Плесень в чашке Петри

Плесневые грибы

Гифальные (плесневые) грибы

Плесень в чашке Петри

Плесневые грибы

Микрофотографии плесени
Бактериологическая плесень

Плесень картинки

Плесневые грибы на хлебе

Плесневые грибы на еде

Плесневые грибы на продуктах

Гриб пеницилл на хлебе

Плесневые грибы на хлебе

Плесневелый гриб пеницилл

Микотоксины плесени

Плесень на продуктах

Плесневые грибы на продуктах

Плесень на фруктах

Плесневые грибы в чашке Петри

Белая плесень на Камне

Красивая плесень

Микроскопические плесневые грибы

Акразиевые слизевики

Плесневые грибы на хлебе

Зеленая плесень

Пеницилл паразит

Разноцветная плесень

Загадочная плесень

Плесневые грибы в почве

Wallemia плесень

Paecilomyces плесень
Плесень текстура
Зеленая плесень пеницилл

Плесневые грибки

Мукор белая плесень гриб

Плесень на хлебе

Плесневые грибы грибы

Грибковая плесень

Wallemia плесень

Wallemia плесень

Мукор белая плесень гриб

Белая плесень

Chromelosporium fulvum

Пыль Макросъемка

Клетка гриба плесень мукор

Плесневые микозы

Плесень в чашке Петри

Плесневые грибы под микроскопом

Плесень Макросъемка

Плесень на продуктах

Penicillium frequentans

Плесневые грибы аэробы
Поделиться фото в социальных сетях:
Комментариев (0)
Похожие фото:











